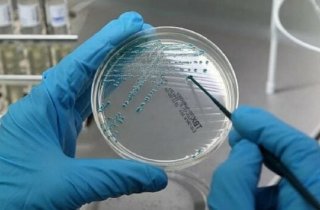
������ ������������ � ����� ����� �������� �������� � �������� ������� ��-�� ������� � �������������� � �����

Специалисты здравоохранения предупреждают о повышенном риске роста заболеваемости острыми кишечными инфекциями (ОКИ) среди населения Одесской области. Ключевым негативным фактором, способствующим этому, названы сложные бытовые условия: нестабильное электроснабжение и периодические перебои с подачей воды и тепла. Об этом сообщили в Одесском областном центре контроля и профилактики болезней.
Специалисты здравоохранения предупреждают о повышенном риске роста заболеваемости острыми кишечными инфекциями (ОКИ) среди населения Одесской области. Ключевым негативным фактором, способствующим этому, названы сложные бытовые условия: нестабильное электроснабжение и периодические перебои с подачей воды и тепла. Об этом сообщили в Одесском областном центре контроля и профилактики болезней.
В учреждении состоялось заседание оперативного штаба в связи с фиксируемым в Украине ростом случаев кишечных инфекций, в том числе во время отдыха. Проанализировав эпидемическую обстановку, медики пришли к выводу, что текущая ситуация с коммунальными услугами в регионе создаёт дополнительные угрозы. Периодическое отсутствие электричества, водоснабжения и отопления в ряде районов затрудняет соблюдение населением базовых гигиенических норм — мытьё рук, продуктов, приготовление безопасной пищи и поддержание чистоты в жилищах. Это значительно повышает вероятность распространения возбудителей кишечных инфекций.
По итогам заседания было принято решение об усилении эпидемиологического надзора и координации между всеми службами для оперативного выявления новых случаев и предотвращения вспышек. В Центре контроля болезней обратились к жителям области с настоятельной просьбой уделять максимум внимания личной гигиене, тщательно следить за качеством питьевой воды и продуктов питания, особенно в условиях перебоев с коммунальными услугами, чтобы минимизировать риски для своего здоровья.
|
Если вы обнаружили ошибку на этой странице, выделите ее и нажмите Ctrl+Enter.
|